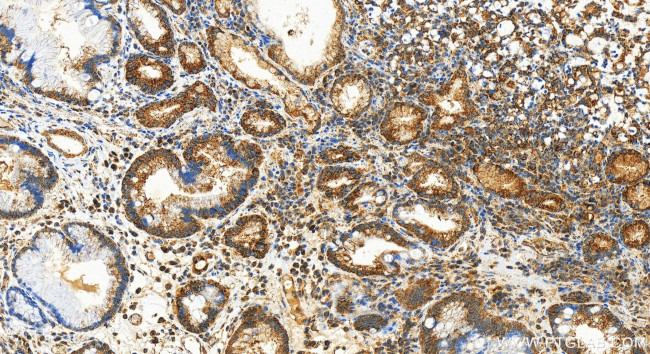
UQCRC2 Antibody in Immunohistochemistry (Paraffin) (IHC (P))

Search
Proteintech
UQCRC2 Recombinant Rabbit Monoclonal Antibody (240454D9)
{{$productOrderCtrl.translations['antibody.pdp.commerceCard.promotion.promotions']}}
{{$productOrderCtrl.translations['antibody.pdp.commerceCard.promotion.viewpromo']}}
{{$productOrderCtrl.translations['antibody.pdp.commerceCard.promotion.promocode']}}: {{promo.promoCode}} {{promo.promoTitle}} {{promo.promoDescription}}. {{$productOrderCtrl.translations['antibody.pdp.commerceCard.promotion.learnmore']}}
产品信息
83667-2-RR
种属反应
宿主/亚型
Expression System
分类
类型
克隆号
抗原
偶联物
形式
浓度
纯化类型
保存液
内含物
保存条件
运输条件
产品详细信息
Immunogen sequence: IEAVGGKLS VTATRENMAY TVECLRGDVD ILMEFLLNVT TAPEFRRWEV ADLQPQLKID KAVAFQNPQT HVIENLHAAA YRNALANPLY CPDYRIGKVT SEELHYFVQN HFTSARMALI GLGVSHPVLK QVAEQFLNMR GGLGLSGAKA NYRGGEIREQ NGDSLVHAAF VAESAVAGSA EANAFSVLQH VLGAGPHVKR GSNTTSHLHQ AVAKATQQPF DVSAFNASYS DSGLFGIYTI SQATAAGDVI KAAYNQVKTI AQGNLSNTDV QAAKNKLKAG YLMSVESSEC FLEEVGSQAL VAGSYMPPST VLQQIDSVAN ADIINAAKKF VSGQKSMAAS GNLGHTPFVD EL
靶标信息
This is a component of the ubiquinol-cytochrome c reductase complex (complex III or cytochrome b-c1 complex), which is part of the mitochondrial respiratory chain. The core protein 2 is required for the assembly of the complex.
仅用于科研。不用于诊断过程。未经明确授权不得转售。
篇参考文献 (0)
生物信息学
蛋白别名: Complex III subunit 2; Core protein II; Cytochrome b-c1 complex subunit 2, mitochondrial; cytochrome bc-1 complex core protein II; U MC3DN5; Ubiquinol-cytochrome-c reductase complex core protein 2
基因别名: MC3DN5; QCR2; UQCR2; UQCRC2
UniProt ID: (Human) P22695
Entrez Gene ID: (Human) 7385